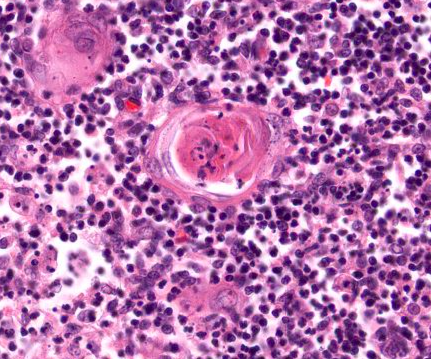

Tipos de inmunidad:
- Innata (inespecífica)
- Específica
Integran la inmunidad innata:
Barreras físicas, defensas químicas, sustancias secretoras. Fagocitos= macrófagos, neutrófilos, NK, mastocitos, c. dendríticas
Principales células efectoras de la inmunidad adaptativa:
Linfocito B reconoce antígeno ➔ célula plasmática = secreta anticuerpos
Anticuerpos son proteínas
Respuesta humoral la llevan a cabo:
Linfocitos B ➔ Células plasmáticas
Requieren de Ig
Inmunidad celular la lleva a cabo
Linfocitos T ➔ citoquinas (median interacciones complejas del sistema inmune
Tipos de tejido linfoide
Presentación del tejido linfoide
- Nodulares encapsulados
- Nodulares no encapsulados
- Difusos
- Pseudoencapsulados
Ubicaciones de nodulares encapsulados:
Timo
Ganglio linfático
Ubicaciones de nodulares NO encapsulados
Íleon = placas de Peyer
Características de tejido linfático difuso:
No forma bolitas
Se encuentra en la mayoría de las mucosas
Dónde se encuentra el tejido linfoide difuso:
Tracto genitourinario, respiratorio y digestivo
Ubicación de pseudoencapsulado
amígdalas palatinas
¿Cómo se conforma el tejido linfoide?
- Estroma: fibras reticulares y células reticulares
- Células: linfocitos B y T + células de sostén
Tipos de estroma:
- Fino: fibras y células reticulares
- Grueso: cápsula, trabéculas e hilio. Cápsula = tejido conj denso irregular
Células de sostén de sistema linfático:
Monocitos, macrófagos, neutrófilos, basófilos, mastocitos y eosinófilos
Órganos linfáticos primarios y secundarios
- Primarios: timo y médula ósea
- Secundarios: ganglios y bazo
V/F en colon y apéndice también encontramos placas de Peyer:
Falso, existe tejido parecido, pero no se llaman placas de Peyer
¿Cómo se conforma el parénquima de un ganglio linfático?
- Corteza (externa e interna) = nódulos linfáticos + tejido linfático difuso
- Médula
V/F el timo desaparece con la edad:
Falso, involuciona, pero no desaparece
¿Qué es?
Corpúsculo de Hasall= células epitelio reticulares tipo VI dispuestas en forma concéntrica con núcleo plano
¿Qué tipos de linfocitos hay en corteza y médula en timo?
- Corteza = inmaduros
- Médula = maduros
Linfocitos T
Órgano

Bazo
Estructuras del bazo:
Pulpa roja: eritrocitos en proceso de destrucción
Pulpa blanca: linfocitos T altamente compactados
Zona marginal
Distintivo entre amígdala palatina y ganglio linfático:
La amígdala tiene epitelio plano estratificado no queratinizado


